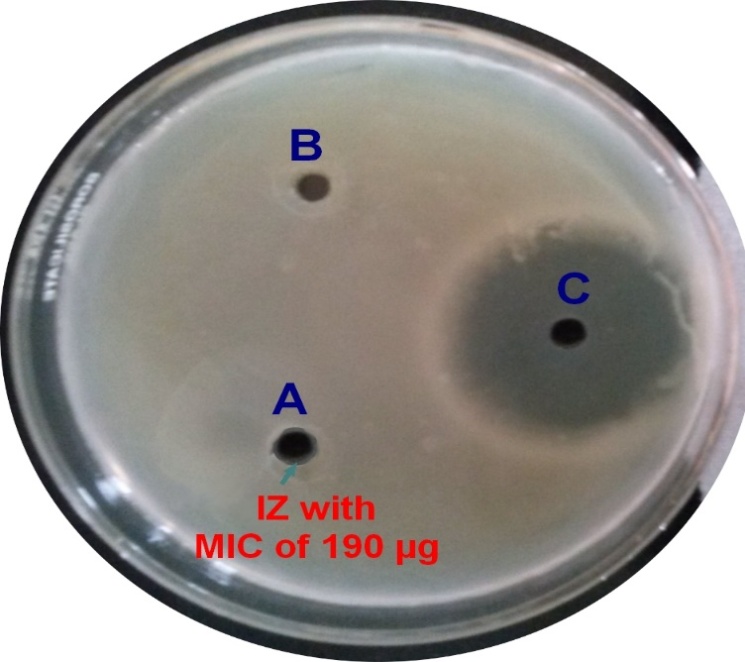

Department of Chemistry, Maharishi Markandeshwar University, Mullana, Ambala 133207, Haryana, India
Email: drrajshreekhare@gmail.com
Received: 16 Feb 2015 Revised and Accepted: 21 May 2015
ABSTRACT
Objective: The metal complexes of 1-(Phenylamino)-4, 4, 6-trimethyl-3, 4-dihydropyrimidine-2-(1H)-thione: preparation, physical and spectroscopic studies and preliminary antibacterial properties.
Methods: Complexes of bidentate ligand containing N, S-bridge [M(pmpt)2(H2O)n] (M(II) = Cu, Mn, Ni, Co; n = 2 and M(II) = Zn, Cd, Pd; n = 0) derived from the reaction of Hpmpt ligand with metals (M(II) = Cu, Mn, Ni, Co, Zn, Cd, Pd) and characterized by various physico-chemical techniques. From magnetic moment studies, square planar geometry is suggested for Zn(II), Cd(II), Pd(II) complexes, octahedral geometry is proposed for Co(II), Ni(II) and Mn(II) and distorted octahedral for Cu(II) complexes. Thermo gravimetric (TG) curves indicate the decomposition of complexes in four to five steps. The presence of coordinated water in metal complexes was confirmed by thermal, elemental analysis and IR data. Free ligand and its complexes were assayed in vitro for their antibacterial activity against gram positive and gram negative bacteria using chloramphenicol as a standard market-drug.
Results: The reported complexes were synthesized through greener protocol that is grindstone method by mixing the ligand and metal salts in 2:1 molar ratio. Products were obtained in good yield with sharp melting point.
Conclusion: Studies have indicated that such complexes can be prepared by environment friendly approach which requires less time, simple workup for isolation and purification with good yield. The [Ni(pmpt)2(H2O)2] complex showed excellent antibacterial activity while other reported metal complexes showed weak antibacterial activity.
Keywords: Synthesis, Pyrimidine-2-(1H)-thione, Antibacterial activity, Thermal study.
INTRODUCTION
Potential ambidentate donors, such as heterocyclic thiones, coordinate through the active site of the exocyclic sulphur and endocyclic non-substituted nitrogen atoms. The extensive corpus of research on the N, S–bridging pyrimidine thione moiety complexes provides evidence for the scintillating significance of their chemistry [1-3] and by extension of their expansive and cumulative applications in organo-catalytic synthesis, bio-clinical innovations [4, 5] such as anticancer agents against Ehrlich ascites tumor cells (EACs) [6] and human breast cancer [MDA-MB231] cell line [7] and even environmental studies to mention a few. As an instance, we have seen many metal complexes involving sulphur donor atom that enhance the biological activity of anticancer and anti-inflammatory agents [8-11]. Furthermore, several proposals regarding the adsorbent properties of heterocyclic thiones in environmental studies have been debated [12].
In this literature, various metal complexes of pyrimidine-2-thione are being examined notably for their biological activities and particularly the coordinating ability of ligands. This research paper reports the synthesis and physico-chemical characterization of Mn(II), Co(II), Ni(II), Cu(II), Zn(II), Cd(II), Pd(II) complexes with 1-(Phenylamino)-4,6-dimethylpyrimidine-2-thione (Hpmpt). All the complexes have been characterized by elemental analysis, magnetic moment, electronic and IR spectroscopy and conductivity. Our findings stimulate us to explore the syntheses of new metal complexes of (Hpmpt) and investigate their antibacterial properties.
MATERIALS AND METHODS
Materials and reagents
All the chemicals used in this investigation were of Analytical grade. Hpmpt was prepared by the reported literature method [13].
Non pathogenic strain of bacteria Escherichia coli was sourced from the department of biotechnology, MMU Mullana. The concerned strain was non pathogenic strain and originally sourced from IMTECH Chandigarh, according to which the strain was designated as MTCC 1195. Bacterial strain was grown in Luria-Bertani (LB) broth media aerobically at 37 ◦C along with shaking at 100 rpm. Cell growth was monitored spectro-photometrically at 600 nm. Media was supplemented with antibiotic like chloramphenicol as a drug of control. pUC 19 plasmid DNA was used to determine the potential photo cleavage activity. The metal contents were estimated using standard gravimetric methods; cobalt was estimated as cobalt pyridine thiocyanate, nickel as nickel dimethyl glyoximate, copper as cuprous thiocyanate and zinc as zinc ammonium phosphate [14].
Melting points were determined in open capillaries in electrical melting point apparatus and are uncorrected. Carbon, hydrogen and nitrogen were estimated using Perkin-Elmer 2400 Elemental analyzer at Panjab University, Chandigarh. Electronic spectra of metal complexes were recorded in DMSO on Schimadzu UV 1800 instrument. IR spectra were recorded on Thermoscientific Nicolet-1S50 FTIR Spectrophotometer affinity in the range of 4000 to 200 cm-1 using KBr pellet. Proton NMR spectra were recorded in DMSO-d6 on a Bruker 400 MHz instrument at 400 MHz using ‘tetramethyl silane’ as internal standard. Mass spectra were recorded on Q-ToF Micro Waters LC-MS spectrometer. Elemental analyses (C, H, N) were carried out using LECO 9320 analyzer. Magnetic moments were measured at IIC, IIT Roorkee on vibrating sample magnetometer (Model 155). The Perkin Elmer (Pyris Diamond) instrument was used to carry out thermal analysis of metal complex in atmospheric air (0–1000 °C) at a heating rate of 10 °C min−1. Molar conductivity measurements were conducted at room temperature on a YSI Model 32 conductivity bridge. Gel electrophoresis cleavage experiments were achieved with the help of Axygen Electrophoretic Unit (horizontal slab) supported by Genei power supply with a potential range 50–500 V.
Synthesis of [M (pmpt)2(H2O)2] (M(II) = Mn, Co, Ni, Cu; n = 2 and M(II) =Zn, Pd, Cd; n = 0)
In the first step ligand (0.01 mol) was mixed with sodium hydroxide (0.01 mol) in 1:1 ratio and dried. In second step 0.05 mol of appropriate metal salt of [Mn (II), Co(II), Ni(II), Cu(II), Zn(II), Cd(II) and Pd(II)] was mixed with the ligand in 2:1 stoichiometric ratio by using the grind stone approach in solvent free conditions. The reaction mixture was dried in oven for 2-3 h and washed with methanol. Dark colored metal complexes obtained were found stable at room temperature.
[Mn(pmpt)2(H2O)2]. H2O: yield = 74% m. pt.-258, (Found: C, 49.29; H, 6.00; N, 13.27; S, 10.11; O, 12.64 % Calcd. for C26H38N6 S2O3Mn: C, 49.2; H, 6.06;N, 13.1; S, 10.09; O, 12.44 %).
[Co(pmpt)2(H2O)2].3.5H2O: yield = 94% m. pt.-283, (Found: C, 48.0; H, 6.61; N, 12.92; S, 9.84; O, 13.53 % Calcd. for C26H43N6 S2O5.5Co: C, 48.09;H, 6.57; N, 12.25; S, 9.34; O, 12.64 %).
[Ni(pmpt)2(H2O)2].2.5H2O: yield = 89% m. pt.-280, (Found: C,49.39; H, 6.49; N, 13.29; S, 10.13; O, 11.39% Calcd. for C26H41N6 S2O4.5Ni: C, 49.20;H, 6.37; N, 13.25; S, 10.03; O, 11.04 %).
[Cu(pmpt)2(H2O)2]. H2O: yield = 90% m. pt.>297, (Found: C, 48.67; H, 5.92; N, 13.10; S, 9.98; O, 12.48 % Calcd. for C26H38N6 S2O5Cu: C, 48.66; H, 5.87; N, 13.14; S, 9.56; O, 12.43 %).
[Zn(pmpt)2].2H2O: yield = 91% m. pt.-288, (Found: C, 52.58; H, 6.06; N, 14.15; S, 10.78; O, 5.39 % Calcd. for C26H36N6 S2O2Zn: C, 52.57; H, 5.98; N, 14.11; S, 10.51; O, 5.21 %).
[Cd(pmpt)2].2H2O: yield = 91% m. pt.-253, (Found: C, 48.75; H, 5.62; N, 13.12; S, 10.0; O, 5.00 % Calcd. for C26H36N6 S2O2Cd: C, 47.98; H, 5.50;N, 13.07; S, 9.87; O, 4.95 %).
[Pd(pmpt)2].2H2O: yield = 88% m. pt.-238, (Found: C, 49.21; H, 5.67; N, 13.24; S, 10.09; O, 5.04 % Calcd. for C26H36N6 S2O2Pd: C, 49.14; H, 5.51;N, 13.20; S, 9.99; O, 4.96 %).
In vitro antibacterial activity
The antibacterial activity of synthesized metal complexes [M(pmpt)2(H2O)n] (M(II) = Cu, Mn, Ni, Co; n = 2 and M(II) = Zn, Cd, Pd; n = 0) was evaluated by agar well diffusion method using DMSO as a solvent against non-pathogenic bacterial strain of E. coli [MTCC-1195]. A medium of 20 ml of Luria agar was poured into each petri plate and the agar plates were swabbed with the test bacterium and kept for 15 min for adsorption. Using sterile cork borer of 10 mm diameter, wells were bored into the seeded agar plates. All the stock solutions of the test compounds and standard were prepared in DMSO at the concentration of 1000 μg/ml. From the stock solution serial dilutions were prepared with known concentration of the compounds (0.2, 0.4,….1 µg/ml). These solutions were loaded to the corresponding wells. All the plates were incubated at 37 °C for 24 h. Anti-bacterial activity of each synthesized compound was evaluated by measuring the zone of growth inhibition with zone reader (Hi Antibiotic zone scale). MIC was considered to be the lowest concentration of the drug or the compound under study that was able to exhibit a visible inhibition zone and below this concentration no inhibition zone is observed. In the present investigation, chloramphenicol was used as reference drug. To conclude, the antibacterial activity growth curve of bacteria was also prepared in the presence and absence of the known concentration of the synthesized compounds[49]. This was achieved using UV spectrophotometric readings taken at frequent and equal interval of the incubating broth kept at shaking conditions of 100 rpm.
Plasmid DNA photo cleavage studies
DNA photo cleavage experiment was performed in a volume of 6 μl containing the plasmid DNA in TE (Tris10 mm, EDTA 0.01 mm, pH 8.0) buffer in the presence of 10-500 μg of the synthesized complexes in different autoclaved PCR tubes. These tubes were placed directly on the surface of the trans-illuminator (8000 mw/cm) at 360 nm. The samples were irradiated for 30 min at room temperature. After irradiation, samples were further incubated at 37 ◦C for 1 h and under visible light. Irradiated samples were mixed with 6X loading dye containing 0.25 % bromophenol blue and 30% glycerol. The samples were then analyzed by electrophoresis on a 0.8% agarose horizontal slab gel in Tris-Acetate EDTA buffer (40 mm Tris, 20 mm acetic acid, 1 mm EDTA, pH: 8.0). Untreated plasmid DNA was maintained as a control in each run of gel electrophoresis which was carried out at 5 V/cm for 2.0 h. Gel was stained with ethidium bromide (1 mg/ml) and photographed under UV gel docking system.
RESULTS AND DISCUSSION
In continuation of our ongoing interest to develop the convenient and efficient methodologies for the biologically active compounds, the scheme for the syntheses of complexes is represented in fig. 1. The formation of metal complexes of Hpmpt has been studied colorimetrically but has not been isolated so far. We report here almost solvent free synthesis of metal complexes of Hpmpt as powdery solids, colored and stable at normal laboratory temperature. The purity of ligands and their metal complexes has been checked by TLC. The present method has many advantages over conventional method like less solvent requirement, no pH adjustment, simple workout, easy operation, eco friendly, less reaction time with better yields of desired products. The elemental analysis also supports the formation in the ratio of 2: 1 metal complexes of Hpmpt with Mn(II), Co(II), Ni(II), Cu(II), Zn(II), Cd(II) and Pd(II) metal ions. All complexes are soluble in DMF and DMSO and insoluble in other common organic solvents (hexane, ethanol, methanol, CHCl3 etc.). The molar conductance values of the complexes (measured in 10−3M DMF) at room temperature lies in the range 6.8–11.3 ohm−1 cm2 mol−1 which suggest that they are non-electrolytes [15-17].
We wished to characterize structurally one of the complexes by X-ray crystallography but were thwarted on numerous junctures by very minute crystal dimensions (lack of single crystals). Thus, the complexes are characterized on the basis of physical and spectroscopic techniques (Tables 1–6).
IR Spectra
The speculative assignments of selected IR bands for all complexes and free Hpmpt are listed in table 2. The free Hpmpt spectra is compared with the spectra of complexes and deuterium isotopic substitution experiment were performed for both free Hpmpt and complexes. It was analysed that dimerisation take place due to disulfide linkage where the sulfur atom behaves as catalytic poison; i.e., suppression of H-D exchange takes place completely[18-19].
The spectra of complexes exhibit relatively sharp band of coordinated water in addition to a medium broad continuous absorption covering the 3445–3371 cm−1 region; this is apparently due to the presence of both crystal and coordinated water in these complexes [20].
The absence of an IR peak at 2600 cm−1 in the spectra of free Hpmpt suggests that the ligand exists in its thione form (see Scheme 1) [21]. Further it is supported by presence of the stretching vibrations due to ν(N(3)-H) and ν(N(1)-N-H) associated with the δ(N(1)-NH) and δ(N(3)-H) deformations [22].
Absence or low frequency of ν(N(3)-H) stretch at 3070 cm−1 and δ(N(3)-H) deformations at 1594 cm−1 in the spectra of complexes pinpoints the involvement of the ring N at 3rd position in coordination. The complex spectra entails interaction between the exocyclic sulfur atom and the metal ions as ν (C=S) bands at 1420 cm−1is absent which is further supported by the presence of systematic shifts of the ν(N(1)-N-H), δ(N(1)-N–H), v(CN) and ν(NCS) and, the appearance of the characteristic thioamide band due to massive coupling of δ(NH), ν(CN), ν(NCS) and ν(C=S) at 1685, 1539, 1420 and 1382, 1266, 1166 cm−1respectively [23–25].
Appearance of ν(C=C) and ν(CN) stretches at or near 1560 cm−1 indicate clearly non-aromatic Behaviou r[6, 7, 15, 16].
Above studies revealed that Hpmpt has behaved as anionic bidentate ligand, coordinating the metal ions through thione S and deprotonated cyclic nitrogen N(3) atom (Figs.2 and 3)[7,15-17,25] forming four membered ring. This feature is supported by the shift observed in the ν(C=S) and ν(N-C=S) stretching modes as well as the absence of the ν (N(3)-H) and δ (N(3)-H) stretches [7]. The Far IR spectra of the complexes shows several bands near 450 and 400 cm-1 due to ν(M-N) and ν(M-S) stretches respectively [7, 17, 26, 30].
1H NMR Spectra
The signals of 1H NMR spectrum of ligand Hpmpt and its complexes [M(pmpt)2(H2O)n] (M(II) = Cu, Mn, Ni, Co; n = 2 and M(II) = Zn, Cd, Pd; n = 0) are given in table 3. The 1H-NMR spectra of Hpmpt shows signal due to 3 (CH3), C=C-H, N(3)-H, N(1)-N-H and a multiplet of Ar C-H; are assigned at δ 1.34, 1.42, 1.48, 4.9 and 8.9, δ 8.6 respectively[24-27, 33, 34]. In the 1H-NMR spectra of [M(pmpt)2(H2O)n] (M(II) = Cu, Mn, Ni, Co; n = 2 and M(II) = Zn, Cd, Pd; n = 0) the singlet due to N(3)-H disappeared while other reported protons are shifted upfield confirming that coordination occurs through deprotonated cyclic N atom at (3rd position) and thione sulfur [31].
NMR spectrum of Cu, Ni complex shows the broad peak due to the paramagnetic behaviour of Cu and Ni metal ions[32]. This observation is in full agreement with the reported results, which further confirm the formation of metal complexes.
Mass spectra
ESI-Mass spectra has supported the molecular ion formation of Hpmpt, [Mn(pmpt)2(H2O)2], [Co(pmpt)2(H2O)2], [Cu(pmpt)2(H2O)2], [Zn(pmpt)2].2H2O and [Pd(pmpt)2].2H2O and [Cd(pmpt)2].2H2O complexes. The mass fragmentation of Hpmpt and selected metal complexes are presented in table 4. An intense molecular ion peak at m/z 248.2 (M++1) in mass spectrum of Hpmpt corresponds to its molecular formula (Calcd. 247).
The spectra of the complexes shows fragmentation patterns corresponding to the successive degradation and stepwise ligand loss of the complex[26]. The mass spectrum of Hpmpt exhibits an intense peak at m/z 248.1 (Calcd. 247), in agreement with the assigned formula [Hpmpt+1]+. The mass spectrum of [Mn(pmpt)2(H2O)2] shows peak at m/z 547.9 (Calcd. 546.9) [Co(pmpt)2(H2O)2] shows peak at m/z 551.4 (Calcd. 550.9) corresponding to molecular ion [Co(pmpt)2]+. Two more peaks at m/z 587.9 and 306 are observed due to [Co(pmpt)2+2 H2O)]+(Calcd. 586.9) and [Co(pmpt)]+(Calcd. 304.9) respectively. The mass spectrum of [Cu(pmpt)2(H2O)2] shows peak at m/z 556.5 (Calcd. 555.5) corresponding to molecular ion [Cu(pmpt)2]+. Another two peaks at m/z 592.5 and 309.5 are also observed due to [Cu(pmpt)2+2H2O]+(Calcd. 591.5) and [Cu(pmpt)]+(Calcd. 309.5) respectively. [Zn(pmpt)2(H2O)2] complex exhibits three peaks at m/z 594.4, 558.4 and 312.4 due to [Zn(pmpt)2+2H2O)]+(Calcd. 593.4) [Zn(pmpt)2]+(Calcd. 558.4) and [Zn(pmpt)]+(Calcd. 311.4) fragments respectively. The spectrum of [Cd(pmpt)2] shows peaks at m/z 642.4 and 359.4 corresponding to [Cd(pmpt)2]+(Calcd. 641.4) and [Cd(pmpt)]+(Calcd. 358.4)fragments. The mass spectrum of [Pd(pmpt)2] shows peak at m/z 599.4 and 353.4 corresponding to [Pd(pmpt)2]+(Calcd. 598.4) and [Pd(pmpt)]+(Calcd. 352.4)fragments respectively[7, 15, 33, 34].
Magnetic measurements and electronic spectra
The magnetic data pertaining to these complexes are given in table 5. The magnetic moment 2.01 BM of Cu(II) complex is indicative of one unpaired electron each in these systems[35,36]. The magnetic data of Ni(II) complex show magnetic moment of 3.11 BM which are close to that of Octahedral d8 system with two unpaired electrons[35,36]. Co(II) complex shows magnetic moment value of 4.19 BM and suggest high spin octahedral geometry with three unpaired electrons in these complexes[35,36]. Mn(II) complex shows magnetic moment value of 5.78 BM and suggested high spin d5 octahedral geometry with five unpaired electrons in these complexes[35,36]. While Zn(II), Cd(II) and Pd(II) have no unpaired electrons thus shows diamagnetic behaviour as expected.
The electronic spectral data of various complexes are presented in table 5. The electronic spectra of Hpmpt and its Mn(II), Co(II), Ni(II), Cu(II), Zn(II), Cd(II) and Pd(II) complexes in DMSO exhibit absorption bands at 289-295 and 305-394 nm that can be assigned to π → π* and n → π* intra-ligand charge transfer respectively [37].
In addition to the above bands [Mn(pmpt)2(H2O)2] complex exhibit d-d transitions of t2g3 eg2 are feeble and spin forbidden, hardly observed even in the concentrated solutions; a weak band at 520 may be assigned to 6A1g → 4T1g(G) transitions respectively[38]. The magnetic moment value of 5.77 BM suggests high spin d5 octahedral geometry with five unpaired electrons for these complexes [38,39,42,43]. Absorptions at 430, 478, 535 for [Co(pmpt)2(H2O)2] complexes were assigned to 4T1g → 4T2g(F),4T1g →4T1g(P), 4T1g →4A2g(F) transitions respectively[41]. 4.19 BM values of magnetic moment suggested high spin octahedral geometry with three unpaired electrons in d7 in these complexes [35, 36].
The electronic spectra of Ni(II) shows band at 919, 753, 485 which are assigned to 3A2g → 3T2g, 3A2g → 3T1g (F), 3A2g → 3T1g (P) and CT transitions of [Ni (pmpt)2(H2O)2], magnetic moment 3.11 BM which is close to octa hectral d8system with two unpaired electrons[27,35,36]. Hence octahedral geometry was proposed for the nickel complex.
The electronic spectra of [Cu(pmpt)2(H2O)2] complex shows CT bands at 702, 543 which are assigned to 2B1g→ 2B2g and 2B2g → 2Eg transitions respectively[42]. The magnetic moment 2.01 BM of Cu(II) complex, is indicative of one unpaired electron in this system[35,36]. Hence, a distorted octahedral geometry was proposed for the Cu(II) complex [36, 43].
Complexes with Zn(II), Cd(II), Pd(II) showed no bands in the visible region as expected for d[10] systems and thus should be diamagnetic. The electronic spectra of diamagnetic [Cd(pmpt)2] complex had to charge transfer transitions from metal to ligand at 465 and 410 respectively[44]. [Pd(pmpt)2] complex displayed two bands at 478 and 435 assigned to 1A1g → 1B1g and 1A1g → 1E2g transitions typical for four coordinate square planar geometry [45, 46]. As the spectra of [Zn(pmpt)2] complex was not well resolved therefore it was not interpreted but its μeff values showed that they are diamagnetic.
Ist Step

LIGAND ANION
2nd step
Scheme 1
Table 1: Colors, melting points and elemental analysis of Hpmpt and its complexes
| Ligand/Complexes | Colour | M. Wt | Found (Calculated) % | M. pt.(°C) |
| C | H | |||
| Hpmpt | cream | 247 | 63.15 (63.13) |
6.88 (6.86) |
| [Mn(pmpt)2(H2O)2]. H2O | pink | 556 | 49.39 (49.2) |
6.00 (6.06) |
| [ Co(pmpt)2(H2O)2].3.5 H2O | violet | 551 | 48.0 (35.09) |
6.61 (6.57) |
| [Ni(pmpt)2(H2O)2].2.5 H2O | green | 550 | 49.39 (49.0) |
6.49 (6.37) |
| [Cu(pmpt)2(H2O)2]. H2O | Light brown | 555.5 | 48.67 (48.7) |
5.92 (5.87) |
| [Zn(pmpt)2]. H2O | white | 558 | 52.58 (52.57) |
6.06 (5.98) |
| [Cd(pmpt)2]. H2O | cream | 606 | 48.75 (47.98) |
5.62 (5.50) |
| [Pd(pmpt)2]. H2O | white | 599 | 49.21 (49.14) |
5.67 (5.51) |
*calculated in parentheses
Table 2: IR spectral data of Hpmpt and its complexes
| Ligand/Complexes | IR Bands (various stretching’s in cm-1) |
| υ (C-S) | |
| Hpmpt | - |
| [Mn(pmpt)2(H2O)2]. H2O | 3371 |
| [Co(pmpt)2(H2O)2].3.5 H2O | 3373 |
| [ Ni(pmpt)2(H2O)2].2.5 H2O | 3435 |
| [Cu(pmpt)2(H2O)2]. H2O | 3373 |
| [Zn(pmpt)2(H2O)2] | 3375 |
| [Cd(pmpt)2(H2O)2] | 3381 |
| [Pd(pmpt)2(H2O)2] | 3439 |
Table 3: 1H NMR data of Hpmpt and its Metal complexes
| Ligand/Complexes | 1H NMR (DMSO-d6) (ppm) |
| Hpmpt | 1.34,1.42,1.48 (s, 9H, 3CH3), 4.9(1H,C=C-H), 8.9(s, N(3)-H), 8.6(s,N(1)-N-H) 7.76-7.91(m,Ar C-H) |
| [Mn(pmpt)2(H2O)2]. H2O | 1.36, 1.39, 1.45 (3 CH3), 4.9(C=C-H), 8.91(N1-N-H) 7.3-7.94 (m, Ar C-H) |
| [Ni(pmpt)2(H2O)2].2.5H2O | 1.16, 1.37, 1.43 (3 CH3), 4.9(C=C-H), 8.94 (N1-N-H) 7.99-8.91 (m, Ar C-H) |
| [Co(pmpt)2(H2O)2].3.5H2O | 1.28, 1.37, 1.43 (3 CH3), 5.0(C=C-H), 8.97 (N1-N-H) 7.4-7.97 (m, Ar C-H) |
| [Cu(pmpt)2(H2O)2]. H2O | 1.14, 1.75, 2.50 (3 CH3), 4.82(C=C-H), 8.2 (N1-N-H) 7.76-7.91(m, Ar C-H) |
| [Zn(pmpt)2(H2O)2] | 1.28, 1.38, 1.43 (3 CH3), 5.02(C=C-H), 8.97(N1-N-H) 7.36-7.99(m, Ar C-H) |
| [Cd(pmpt)2(H2O)2] | 1.30, 1.39, 1.42 (3 CH3), 4.83(C=C-H), 8.93 (N1-N-H) 7.78-7.91(m, Ar C-H) |
| [Pd(pmpt)2(H2O)2] | 1.27, 1.37, 1.43 (3 CH3), 5.02(C=C-H), 8.96(N1-N-H) 7.38-7.99(m, Ar C-H) |
Table 4: Mass fragmentation data of Hpmpt and its metal complexes (M++1) mode
| Ligand/Complexes | (M++1) mode |
| Hpmpt | 93, 167, 215, 248 |
| [Mn(pmpt)2(H2O)2]. H2O | 547.9, 551.4 |
| [Ni(pmpt)2(H2O)2].2.5H2O | 247, 283, 306, 552, 607 |
| [Co(pmpt)2(H2O)2].3.5H2O | 306, 587.3 |
| [Cu(pmpt)2(H2O)2]. H2O | 309.5, 556.5, 592.5 |
| [Zn(pmpt)2].2H2O | 312.4, 558.4, 594.4 |
| [Cd(pmpt)2].2H2O | 359.4, 642.4 |
| [Pd(pmpt)2].2H2O | 353.4, 599.4 |
Table 5: The electronic absorption and Magnetic moment data (nm) of Hpmpt and its metal complexes
| Ligand/Complexes | Magnetic moments/B. M. |
Transitions λmax nm (cm-1) |
| Hpmpt | - | 305(32786), 229(43668) |
| [Mn(pmpt)2(H2O)2]. H2O | 5.77 (Octahedral) | 520 (19230), 310 (32258), 307(32573), 289.7(34602) |
| [Ni(pmpt)2(H2O)2].2.5H2O | 3.11 (Octahedral) | 914(10940), 430(23255), 340(29411), 290(34482) |
| [Co(pmpt)2(H2O)2].3.5H2O | 4.19 (Octahedral) | 535(18691), 478(20920), 430(23255), 307(32573), 289(34602) |
| [Cu(pmpt)2(H2O)2]. H2O | 2.01(distorted Octahedral) | 919(10881), 753(13280), 485(20618) |
| [Zn(pmpt)2].2H2O | Diamagnetic | 340(29411.76), 295(29411) |
| [Cd(pmpt)2].2H2O | Diamagnetic | 465(21505), 410(24390), 342(29239) |
| [Pd(pmpt)2].2H2O | Diamagnetic | 478(21231), 332(30120) |
Table 6: Thermogravimetric data of [Mn (pmpt)2(H2O)2]. H2O, [Cu(pmpt)2(H2O)2]. H2O, [Co(pmpt)2(H2O)2].3.5H2O, [Ni(pmpt)2(H2O)2].2.5H2O complexes
| Compound | Decomposition stages and assignment | Temp. (◦C) % | Weight loss found (Calcd.) |
[Mn(pmpt)2(H2O)2]. H2O [C26H38N6MnO3S2] |
1)Lattice water (hydrated water) | 0-80 | 2.9(3.1) |
2)Coordinated water (inside coordination sphere) |
80-140 | 5.09(4.7) | |
| 3)C7H10N2 elimination | 140-370 | 20.5(20.3) | |
| 4)C6H6N | 370-500 | 15.1(15.3) | |
| 5) C13H16N3 elimination | 500-800 | 35.8(35.6) | |
[Co(pmpt)2(H2O)2].3.5H2O [C26H43N6CoO5.5S2] |
1) Lattice water (hydrated water) | 0-85 | 9.7(9.69) |
| 2) Coordinated water | 85-150 | 5.53(5.5) | |
| 3) C6H11N2 elimination | 150-350 | 18.9(18.8) | |
4) C6H6S 5) C13H16N3 elimination (inside coordination sphere) |
350-460 460-800 |
14.15(14.0) 32.9(33.0) |
|
[Ni(pmpt)2(H2O)2].2.5H2O [C26H41N6NiO4.5S2] |
1) Lattice water (hydrated water) | 0-70 | 7.0(7.1) |
2) Coordinated water (inside coordination sphere) |
70-140 | 5.8(5.71) | |
| 3) C7H10N2 elimination | 140-280 | 19.5(19.37) | |
| 4) C6H5N | 280-425 | 14.4(14.45) | |
| 5) C13H17N3 elimination | 425-800 | 34.0(34.15) | |
| [Cu(pmpt)2(H2O)2]. H2O [C26H38N6CuO3S2] | 1) Lattice water (hydrated water) | 0-70 | 3.0(2.9) |
2) Coordinated water (inside coordination sphere)+N2 |
70-150 | 6.0(5.9) | |
| 3) C6H4N3O2 elimination | 150-270 | 20.1(20.0) | |
| 4) C7H10S | 270-450 | 15.1(15.09) | |
| 5) C12H14N4O4 S elimination | 450-800 | 35.2(35.27) |
*calculated in parentheses
Thermal studies
Thermal stability and degradation behavior of complexes [Mn(pmpt)2(H2O)2]. H2O, [Cu(pmpt)2(H2O)2]. H2O, [Co(pmpt)2 (H2O)2]. 3.5H2O, [Ni(pmpt)2(H2O)2].2.5H2O was established using thermo gravimetric (TG) technique. Primary thermal data is listed in table 6.
It is observed that the loss of weight below 140 °C in some of the complex is due to dehydration resulting into change of color from light to dark [6, 34, 48].
From TG curves, four stages of decomposition was observed starting from the loss of hydrated water, coordinated water and decomposition of pmpt-moiety which is due to the break-down of the weak hetero {HN-C(ph), HN-N(1) or N(1)-CS or S-N(3)} bonds [26, 48].
The thermogram of [Mn(nmpt)2(H2O)2]. H2O displays five stages of weight loss in 10-80, 80-140, 140-370, 370-500 and 500-800 °C regions. These weight losses are ascribed to elimination of hydrated water (Calcd. 3.1%, Found 2.8%), coordinated water molecules, (Calcd. 4.7%, Found 5.07%), C7H10N2 moiety (Calcd. 20.3%, Found 20.5%), C6H6N moiety (Calcd. 15.3%, Found 15.1%), C13H16N3 moiety (Calcd. 35.6%, Found 35.8%), leaving the mixture of MnO, MnS and MnC 2[26, 48].
[Cu(pmpt)2(H2O)2]. H2O shows five TG inflections in the 0–70, 70–140, 140–270 and 270–450, 450-800 °C regions. The weight loss reveals the elimination of one lattice water molecule (Calcd. 20.0%, Found 20.1%), two coordinated water molecules (Calcd. 5.9%, Found 6.0%), C7H10N2 moiety (Calcd. 17.4%, Found 17.6%), C6H6N moiety (Calcd. 15.09%, Found 15.1%), C13H17N3 fragments (Calcd. 35.27%, Found 35.2%), leaving CuO residue contaminated with carbide and sulfide [26, 48].
[Ni(pmpt)2(H2O)2].2.5H2O thermogram displays five TG inflections in the 0–70, 70–140, 140–280 and 280–425, 425-800 °C regions. Elimination of 2.5 lattice water molecules (Calcd. 7.1%, Found 7.0%), two coordinated water molecules (Calcd. 5.7%, Found 5.8%), C7H11N2 moiety (Calcd. 19.4%, Found 19.5%), C6H5N moiety (Calcd. 14.45%, Found 14.4%), C13H17N3 fragments (Calcd. 34.2%, Found 34.0%) shows weight losses leaving contaminated mixture of NiO with carbide and sulfide [26, 48].
The thermogram of [Co(pmpt)2(H2O)2].3.5H2O illustrates five TG weight losses in ranges 0–80, 80–150, 150–350 and 250–460, 460-800 °C. The first weight loss was endothermic which may be due to the release of 3.5 lattice water (Calcd. 9.69%, Found 9.7%), second exothermic due to two coordinated water molecules (Calcd. 5.53%, Found 5.5%), third one is due to C7H11N2 moiety (Calcd. 18.9%, Found 18.8%) while fourth and fifth indicates the elimination of C6H6N moiety (Calcd. 14.15%, Found 14.0%) and C13H16N3 fragments (Calcd. 32.9%, Found 33.0%) leaving CoO+CoS+CoC2 residue.
Biological assay
Anti-bacterial Activity
All the six complexes, [M(pmpt)2(H2O)2] (M(II) = Mn, Co, Ni, Zn), [Pd(pmpt)2] and [Cd(pmpt)2] were synthesized and subjected to the biological activities that they can exhibit. The major purpose of this study was to determine the potential of compounds which can inhibit the bacterial growth under stressed and non-stressed conditions. All the complexes were serially diluted in a fix proportion with DMSO such that every µl of the solution mix had five µg of the complex. This solution was subjected to the MIC test for non-pathogenic bacteria i.e. Escherichia coli (MTCC-1195) using well diffusion method. It was revealed that [Ni(pmpt)2(H2O)2] complex exhibited antibacterial activity to the good extent, whereas the rest of the compounds failed to be active against the respective strain of bacteria. Nickel complex gives a MIC of 190 µg against the bacteria. In to, it was further discovered that 400 µg of the complex (dissolved in DMSO) revealing the above mentioned MIC is added to the 25 ml autoclaved LB broth (forming an emulsion) and inoculated with the respective bacteria, log phase of growth curve declines and is prolonged. In control conditions, the mid log phase ends at 18th h with spectrophotometric readings 0.744 (@600 nm) but when the complex is present, range of mid log phase extends to 20th h and surprisingly at 18th h the spectrophotometric reading is 0.638. These observations are illustrated in the graph given below.

Fig. 1: Growth curve of MTCC-1195 strain of bacteria under control condition (1195[C]) and supplemented condition (1195[S])
When the MIC of this complex is compared with chloramphenicol activity (positive control) against the same bacteria, it was revealed that chloramphenicol exhibits MIC at 90 µg. There was very interesting observation that MIC for chloramphenicol against this bacterium at lower pH of 6 was 140 µg however the compound under study retained the efficiency. In altered conditions of low pH too the compound revealed MIC values with slight elevations in dose i.e. 195 µg. This negligible variation could be explained on account of experimental replication error. Hence the compound proves useful as far as resistance of bacteria is a matter of concern and the result also indicate that there may be two different mechanisms responsible for the bacterial activity under stressful conditions.
Fig. 2: Agar plate exhibiting the (A) Inhibition zone produced revealing the MIC value of 190 µg for [Ni(pmpt)2(H2O)2] complex, (B) No inhibition zone produced when DMSO alone is poured in the well and (C) Inhibition zone produced when similar quantity i.e. 190 µg of chloramphenicol is poured in well
Photo cleavage activity was determined using pUC19 plasmid DNA in the present study. The complexes were dissolved in DMSO such that each µl of the solution mix had 10-500 µg of the complex in separate reaction mixtures. 6 µg of the plasmid DNA was subjected to the concerned activity at various concentrations of the compound. It was noted that all the complexes fail to exhibit nicking activity up to 400 µg and none of the forms i.e. Form I or II were visualized in gel dock. However complexes reveal DNA digestion after 600 µg.
CONCLUSION
The present research reports the eco friendly protocol to synthesize metal complexes with Hpmpt ligand. Bidentate Hpmpt ligand shows coordination mode through thione sulfur and deprotonated cyclic nitrogen N(3) center. All the metal complexes were characterized on the basis of various spectroscopic techniques which enable us to propose the possible structure of complexes. However, no crystal can be isolated from complex thus no exact structure could be described. [Ni(pmpt)2(H2O)2] complex were found to possess a satisfactory level of biological activity. However, other complexes were not effective. Attempts will be made to grow crystals in near future.
ACKNOWLEDGEMENT
Financial support from Management of Maharishi Markandeshwar University Education Trust is highly acknowledged.
CONFLICT OF INTERESTS
Declared None
REFERENCES